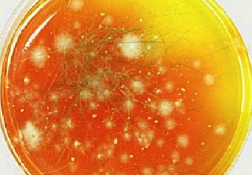

真菌培養&同定
いつ行うか?
- 真菌感染の疑いがあるすべての患畜
何を見つけるか?
- 白色の不鮮明なコロニーで、黄色がかった反転色素を伴う。
- 壁の厚い紡錘形の大分生子で末端に節があり、一般に6つ以上の内部コンパートメントに分かれている。
- 顆粒状のベージュ色の培養物で黄色がかった反転色素を呈する。
- 6つ以下の内部コンパートメントに分かれた壁の薄い大分生子が多数みられる。
- 白色粉状のコロニー
- 葉巻形の大分生子の数はきわめて少なく、小型の円形小分生子が多数みられる。
何が必要か?
- 皮膚糸状菌試験用培地(DTM)、透明な粘着テープ、スライド、顕微鏡、メチレンブルーまたはDiffQuick®ブルー
どのように行うか?
- 水をつけたメスを用いて擦り、止血鉗子を用いて引き抜く;病変の端から被毛および鱗屑を採取する(ウッド灯下で蛍光を発する病変が望ましい)。
- DTMに被毛および鱗屑を軽く押し当てるように設置する;フタを固く締めないこと。
- DTMを20~25℃でインキュベートする(湿気のある暖かい場所がよい)。DTMは、3週間、毎日確認する。
- コロニーがまだ小さいうちに培地の色の変化(pH変化)が起こり、その後コロニーが成長するにつれて広がる場合は、皮膚糸状菌が存在することを示している。
- コロニー発生後10~14日が経過したら、疑わしいコロニーに透明な粘着テープを(粘着側を下向きにして)軽く押し当てる。スライド上にメチレンブルーなどの染色液1滴を垂らし、採取したコロニーを植え付ける。
- コンデンサを上げた顕微鏡下で検体を評価する。粘着テープはカバーガラスと同じように機能する。
ヒント
- 患畜が明確な境界のある病変を有していないか、無症候性保菌者であることが疑われる場合、マッケンジーの歯ブラシ法を用いる。
- 新しい歯ブラシで被毛を約5分間ブラッシングする。
- 滅菌済みの針を用いて被毛および鱗屑を寒天上にそっと置くか、剛毛を滅菌済みのハサミで切断する。
- すべての材料(剛毛、被毛、鱗屑)を寒天上に置く。
- 腐生菌コロニーでも寒天の色変化がみられることがあり、特に腐生菌が古くなると顕著になる。培養物の増殖に伴う色変化に気づくためには、毎日培養物を調査することが不可欠である。
abscess
A discrete swelling containing purulent material, typically in the subcutis
Perianal abscess in a dog
alopecia
Absence of hair from areas where it is normally present; may be due to folliculitis, abnormal follicle cycling, or self-trauma
Extensive alopecia secondary to cutaneous epitheliotropic lymphoma
alopecia (“moth-eaten”)
well-circumscribed, circular, patchy to coalescing alopecia, often associated with folliculitis
“Moth-eaten” alopecia secondary to superficial bacterial folliculitis
hemorrhagic bullae
Blood-filled elevation of epidermis, >1cm
Interdigital hemorrhagic bulla in a dog with deep pyoderma and furunculosis
comedo
dilated hair follicle filled with keratin, sebum
Comedones on the ventral abdomen of a dog with hypercortisolism
crust
Dried exudate and keratinous debris on skin surface
Multifocal crusts due to pemphigus foliaceus
epidermal collarettes
Circular scale or crust with erythema, associated with folliculitis or ruptured pustules or vesicles
Epidermal collarettes in a dog with Staphylococcus superficial bacterial folliculitis
erosion
Defect in epidermis that does not penetrate basement membrane. Histopathology may be needed to differentiate from ulcer.
Erosions in a dog with vasculitis
erythema
Red appearance of skin due to inflammation, capillary congestion
Erythema in a dog with cutaneous drug eruption
eschar
Thick crust often related to necrosis, trauma, or thermal/chemical burn
Eschar from physical trauma
excoriation
Erosions and/or ulcerations due to self-trauma
Excoriations in a cat with atopic dermatitis
fissure
Excessive stratum corneum, confirmed via histopathology. This term is often used to describe the nasal planum and footpads.
Fissures of the footpads in a dog with superficial necrolytic dermatitis
fistula
Ulcer on skin surface that originates from and is contiguous with tracts extending into deeper, typically subcutaneous tissues
Perianal fistulas in a dog
follicular casts
Accumulation of scale adherent to hair shaft
Follicular casts surrounding hairs from a dog with hypothyroidism
hyperkeratosis
Excessive stratum corneum, confirmed via histopathology. This term is often used to describe the nasal planum and footpads.
Idiopathic hyperkeratosis of the nasal planum (left) and footpads (right)
hyperpigmentation
Increased melanin in skin, often secondary to inflammation
Inflammatory lesions (left) resulting in post-inflammatory hyperpigmentation (right)
hypotrichosis
Lack of hair due to genetic factors or defects in embryogenesis.
Congenital hypotrichosis in chocolate Labrador puppies.
lichenification
Thickening of the epidermis, often due to chronic inflammation resulting in exaggerated texture
Lichenification of skin in a dog with chronic atopic dermatitis and Malassezia dermatitis
macule
Flat lesion associated with color change <1cm
Pigmented macule (left) Erythematous macule (right)
melanosis
Increased melanin in skin, may be secondary to inflammation.
Post inflammatory hyperpigmentation of this dog’s thigh
miliary
Multifocal, papular, crusting dermatitis; a descriptive term, not a diagnosis
Miliary dermatitis in a flea allergic cat
morbiliform
A erythematous, macular, papular rash; the erythematous macules are typically 2-10 mm in diameter with coalescence to form larger lesions in some areas
Morbiliform eruptions in a dog with a cutaneous drug reaction
onychodystrophy
Abnormal nail morphology due to nail bed infection, inflammation, or trauma; may include: Onychogryphosis, Onychomadesis, Onychorrhexis, Onychoschizia
Onychodystrophy in dog with chronic allergies
onychogryphosis
Abnormal claw curvature; secondary to nail bed inflammation or trauma
Onychogryphosis in a dog with symmetric lupoid onychodystrophy
onychomadesis
Claw sloughing due to nail bed inflammation or trauma
Onychomadesis in a dog with symmetric lupoid onychodystrophy
onychorrhexis
Claw fragmentation due to nail bed inflammation or trauma
Onychorrhexis in a dog with symmetric lupoid onychodystrophy
onychoschizia
Claw splitting due to nail bed inflammation or trauma
Onychoschizia in a dog with symmetric lupoid onychodystrophy
patch
Flat lesion associated with color change >1cm
Hypopigmented patch (left), erythematous patch (right)
petechiae
Small erythematous or violaceous lesions due to dermal bleeding
Petechiae in a dog with cutaneous vasculitis
phlebectasia
Venous dilation; most commonly associated with hypercortisolism
Phlebectasia and cutaneous atrophy due to hypercortisolism in a dog
plaques
Flat-topped elevation >1cm formed of coalescing papules or dermal infiltration
Plaques in a cat with cutaneous lymphoma
pustule
Raised epidermal infiltration of pus
Pustules on the abdomen of a dog with superficial staphylococcal pyoderma.
scale
Accumulation of loose fragments of stratum corneum
Loose, large scales due to ichthyosis in a Golden Retriever
scar
Fibrous tissue replacing damaged cutaneous and/or subcutaneous tissues
Scarring (right) following the healing of an ulcer (left) in a dog with sterile nodular dermatitis
serpiginous
Undulating, serpentine (snake-like) arrangement of lesions
Serpiginous urticarial lesions on a horse
telangiectasia
Permanent enlargement of vessels resulting in a red or violet lesion (rare)
Telangiectasia in a dog with angiomatosis
ulcer
A defect in epidermis that penetrates the basement membrane. Histopathology may be needed to differentiate from an erosion.
Ulcerations of the skin of a dog with vasculitis.
urticaria
Wheals (steep-walled, circumscribed elevation in the skin due to edema ) due to hypersensitivity reaction
Urticaria in a horse
vesicle
Fluid-filled elevation of epidermis, <1cm
Vesicles and bullae on ear pinna due to bullous pemphigoid
wheal
Steep-walled, circumscribed elevation in the skin due to edema
Wheals associated with intradermal allergy testing in a horse